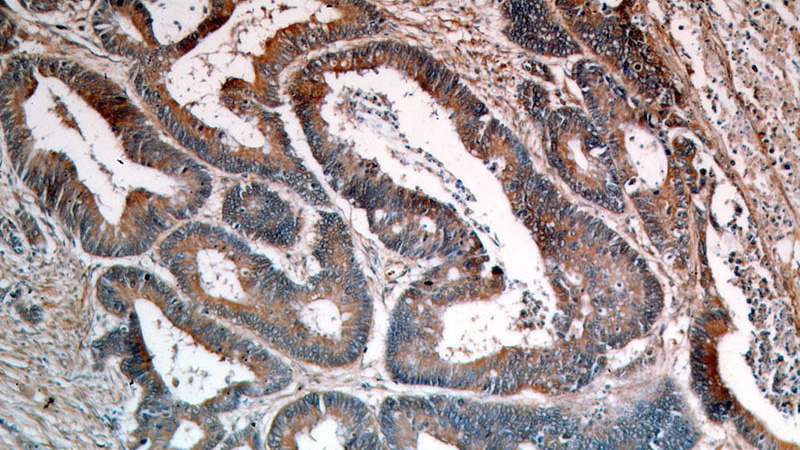
Immunohistochemical of paraffin-embedded human colon cancer using Catalog No:113989(PDPN,D2-40,M2A antibody) at dilution of 1:50 (under 10x lens)

-
Product Name
Podoplanin antibody
- Documents
-
Description
Podoplanin Rabbit Polyclonal antibody. Positive FC detected in HUVEC cells. Positive IHC detected in human colon cancer tissue, human lung tissue, human skeletal muscle tissue. Positive WB detected in HEK-293 cells, human placenta tissue, Transfected HEK-293 cells. Observed molecular weight by Western-blot: 43 kDa
-
Tested applications
ELISA, IHC, WB, FC
-
Species reactivity
Human; other species not tested.
-
Alternative names
AGGRUS antibody; D2 40 antibody; D2 40 antibody; M2A antibody; Glycoprotein 36 antibody; GP36 antibody; Gp38 antibody; GP40 antibody; HT1A 1 antibody; M2A antibody; OTS8 antibody; PA2.26 antibody; PA2.26 antigen antibody; PDPN antibody; podoplanin antibody; PSEC0025 antibody; T1 alpha antibody; T1A antibody; T1A 2 antibody
-
Isotype
Rabbit IgG
-
Preparation
This antibody was obtained by immunization of Podoplanin recombinant protein (Accession Number: BC022812). Purification method: Antigen affinity purified.
-
Clonality
Polyclonal
-
Formulation
PBS with 0.1% sodium azide and 50% glycerol pH 7.3.
-
Storage instructions
Store at -20℃. DO NOT ALIQUOT
-
Applications
Recommended Dilution:
WB: 1:500-1:5000
IHC: 1:20-1:200
-
Validations

HEK-293 cells were subjected to SDS PAGE followed by western blot with Catalog No:113989(PDPN,D2-40,M2A Antibody) at dilution of 1:1000
Immunohistochemical of paraffin-embedded human colon cancer using Catalog No:113989(PDPN,D2-40,M2A antibody) at dilution of 1:50 (under 10x lens)

Immunohistochemical of paraffin-embedded human colon cancer using Catalog No:113989(PDPN,D2-40,M2A antibody) at dilution of 1:50 (under 40x lens)

Transfected HEK-293 cells were subjected to SDS PAGE followed by western blot with Catalog No:113989(PDPN,D2-40,M2A Antibody) at dilution of 1:1000

1X10^6 HUVEC cells were stained with 0.2ug PDPN,D2-40,M2A antibody (Catalog No:113989, red) and control antibody (blue). Fixed with 4% PFA blocked with 3% BSA (30 min). Alexa Fluor 488-congugated AffiniPure Goat Anti-Rabbit IgG(H+L) with dilution 1:1500.
-
Background
M2A(D2-40) antigen is a previously identified marker for CIS and seminoma. M2A (D2-40) antigen has been identical to PDPN.(PMID: 16736189). PDPN, also named as GP36, Gp38, GP40, HT1A-1, OTS8, PA2.26, T1A and T1A-2, has a function in developing testis, most likely at the level of cell-cell interactions among pre-meiotic germ cells and immature Sertoli cells. It may be involved in cell migration and/or actin cytoskeleton organization. When expressed in keratinocytes, PDPN induces changes in cell morphology with transfected cells showing an elongated shape, numerous membrane protrusions, major reorganization of the actin cytoskeleton, increased motility and decreased cell adhesion. It is required for normal lung cell proliferation and alveolus formation at birth. PDPN induces platelet aggregation. It does not have any effect on folic acid or amino acid transport and does not function as a water channel or as a regulator of aquaporin-type water channels. The antibody is specific to Podoplanin.
-
References
- Zhang X, Wang J, Ding X. Altered expression of podoplanin in keratocystic odontogenic tumours following decompression. Oncology letters. 7(3):627-630. 2014.
- Feng Y, Dorhoi A, Mollenkopf HJ. Platelets direct monocyte differentiation into epithelioid-like multinucleated giant foam cells with suppressive capacity upon mycobacterial stimulation. The Journal of infectious diseases. 210(11):1700-10. 2014.
Related Products / Services
Please note: All products are "FOR RESEARCH USE ONLY AND ARE NOT INTENDED FOR DIAGNOSTIC OR THERAPEUTIC USE"
